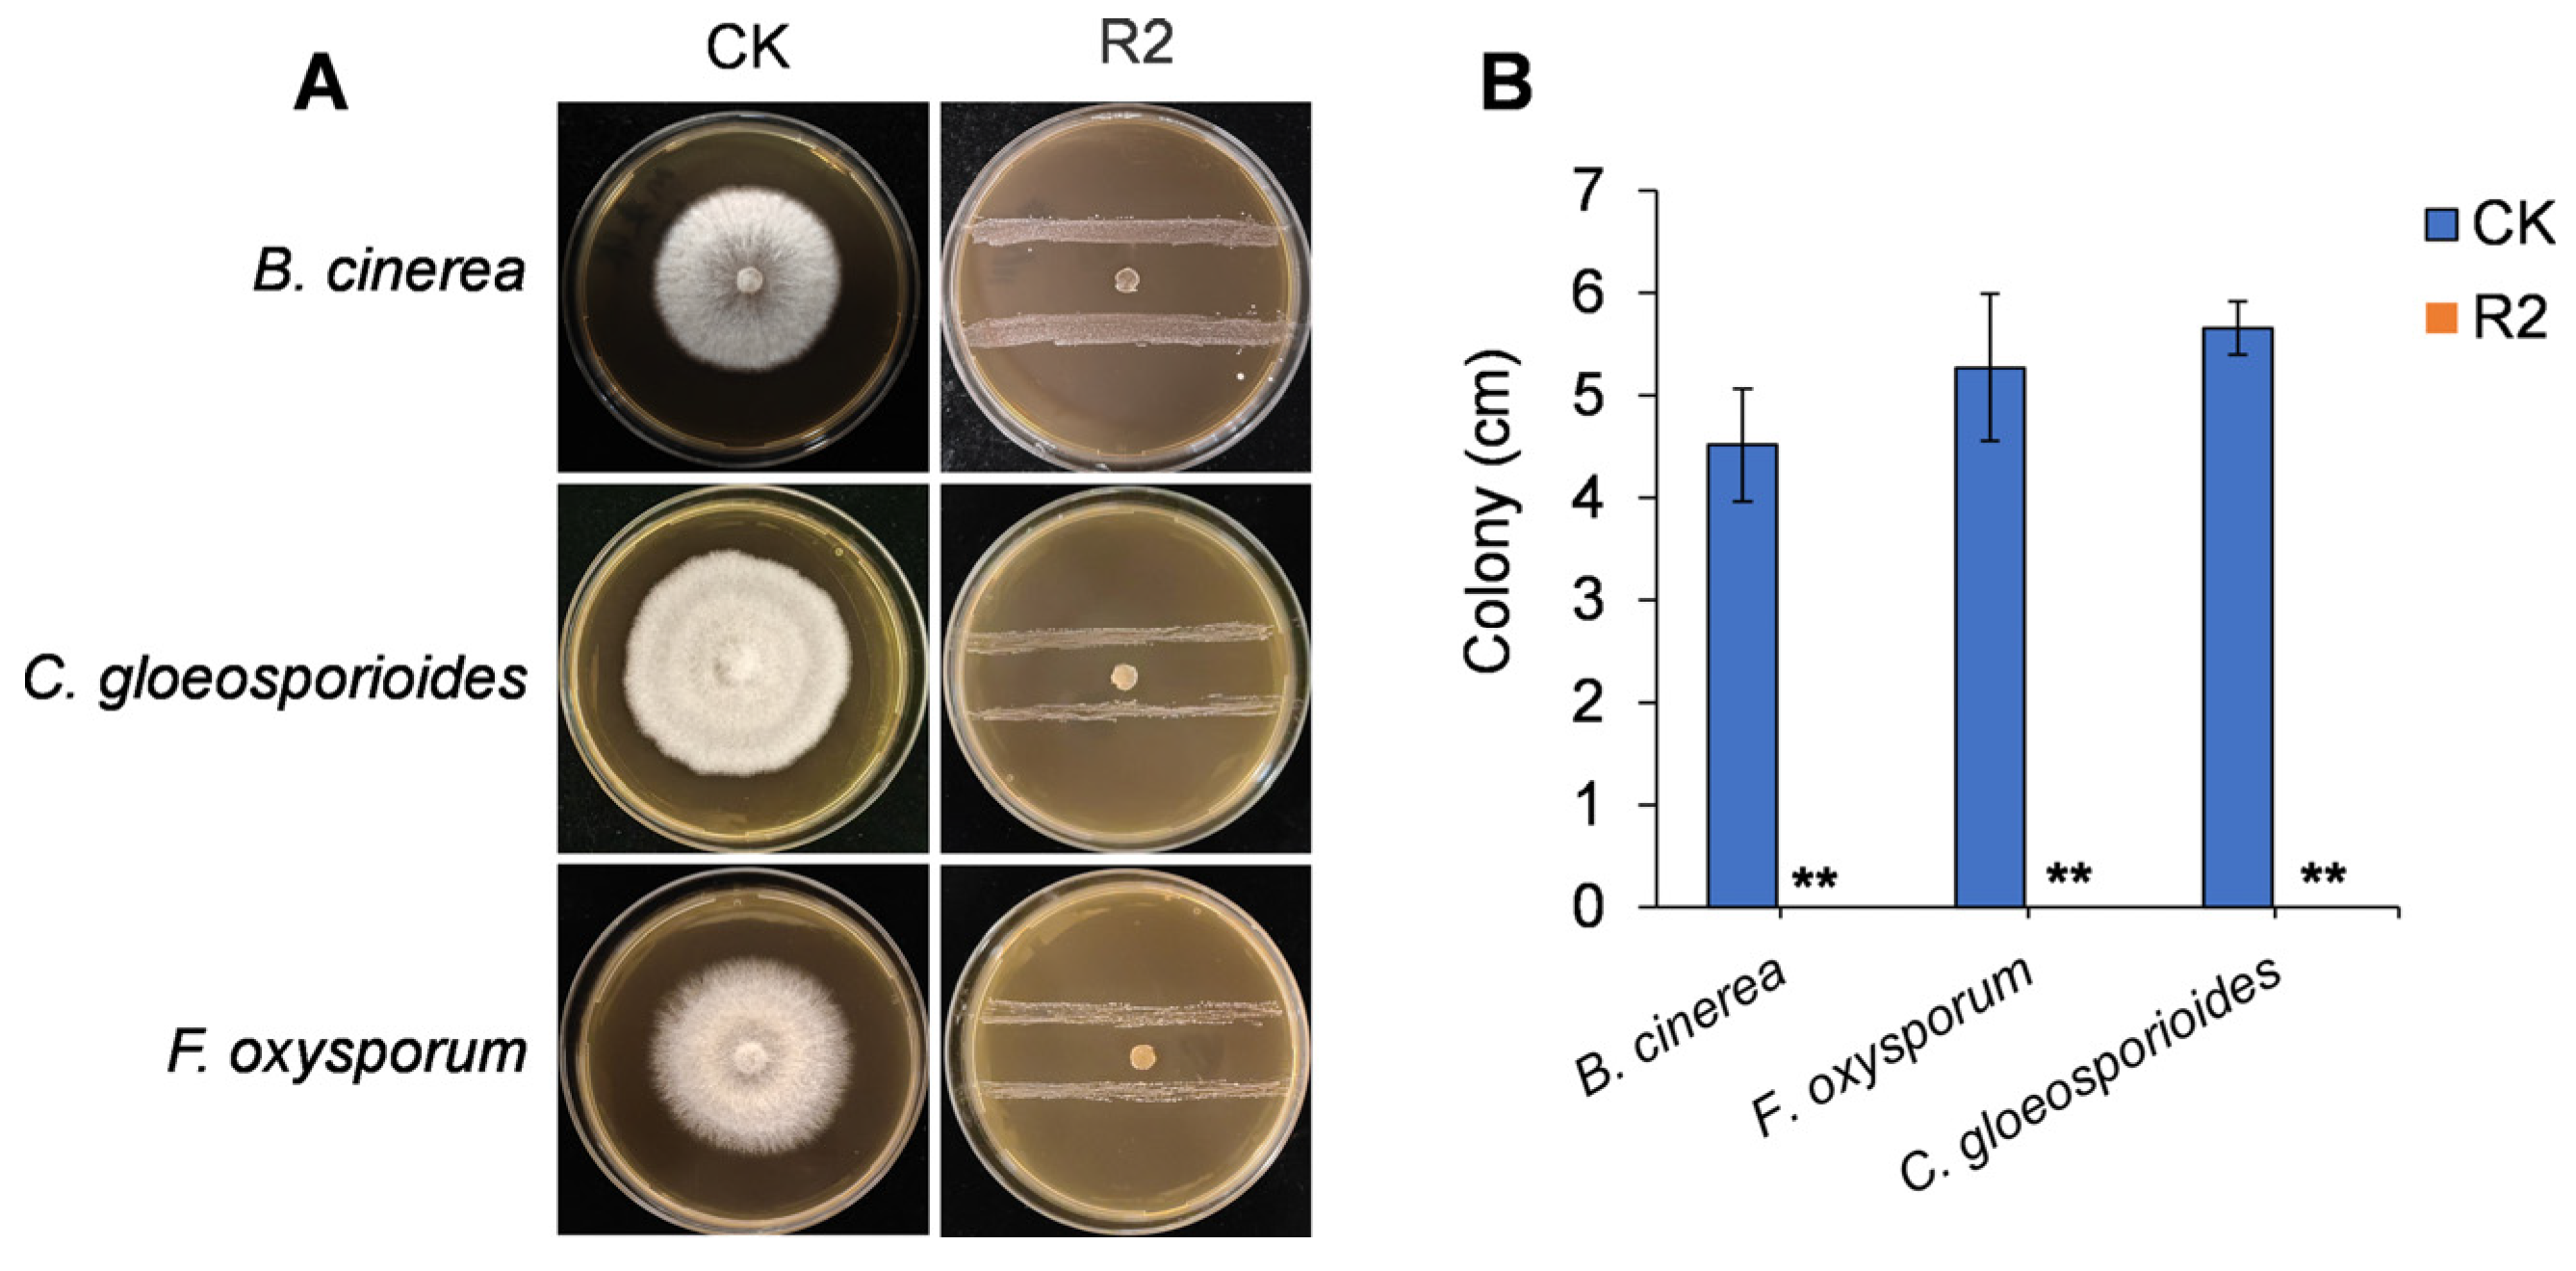
Jof 11 00538 g001
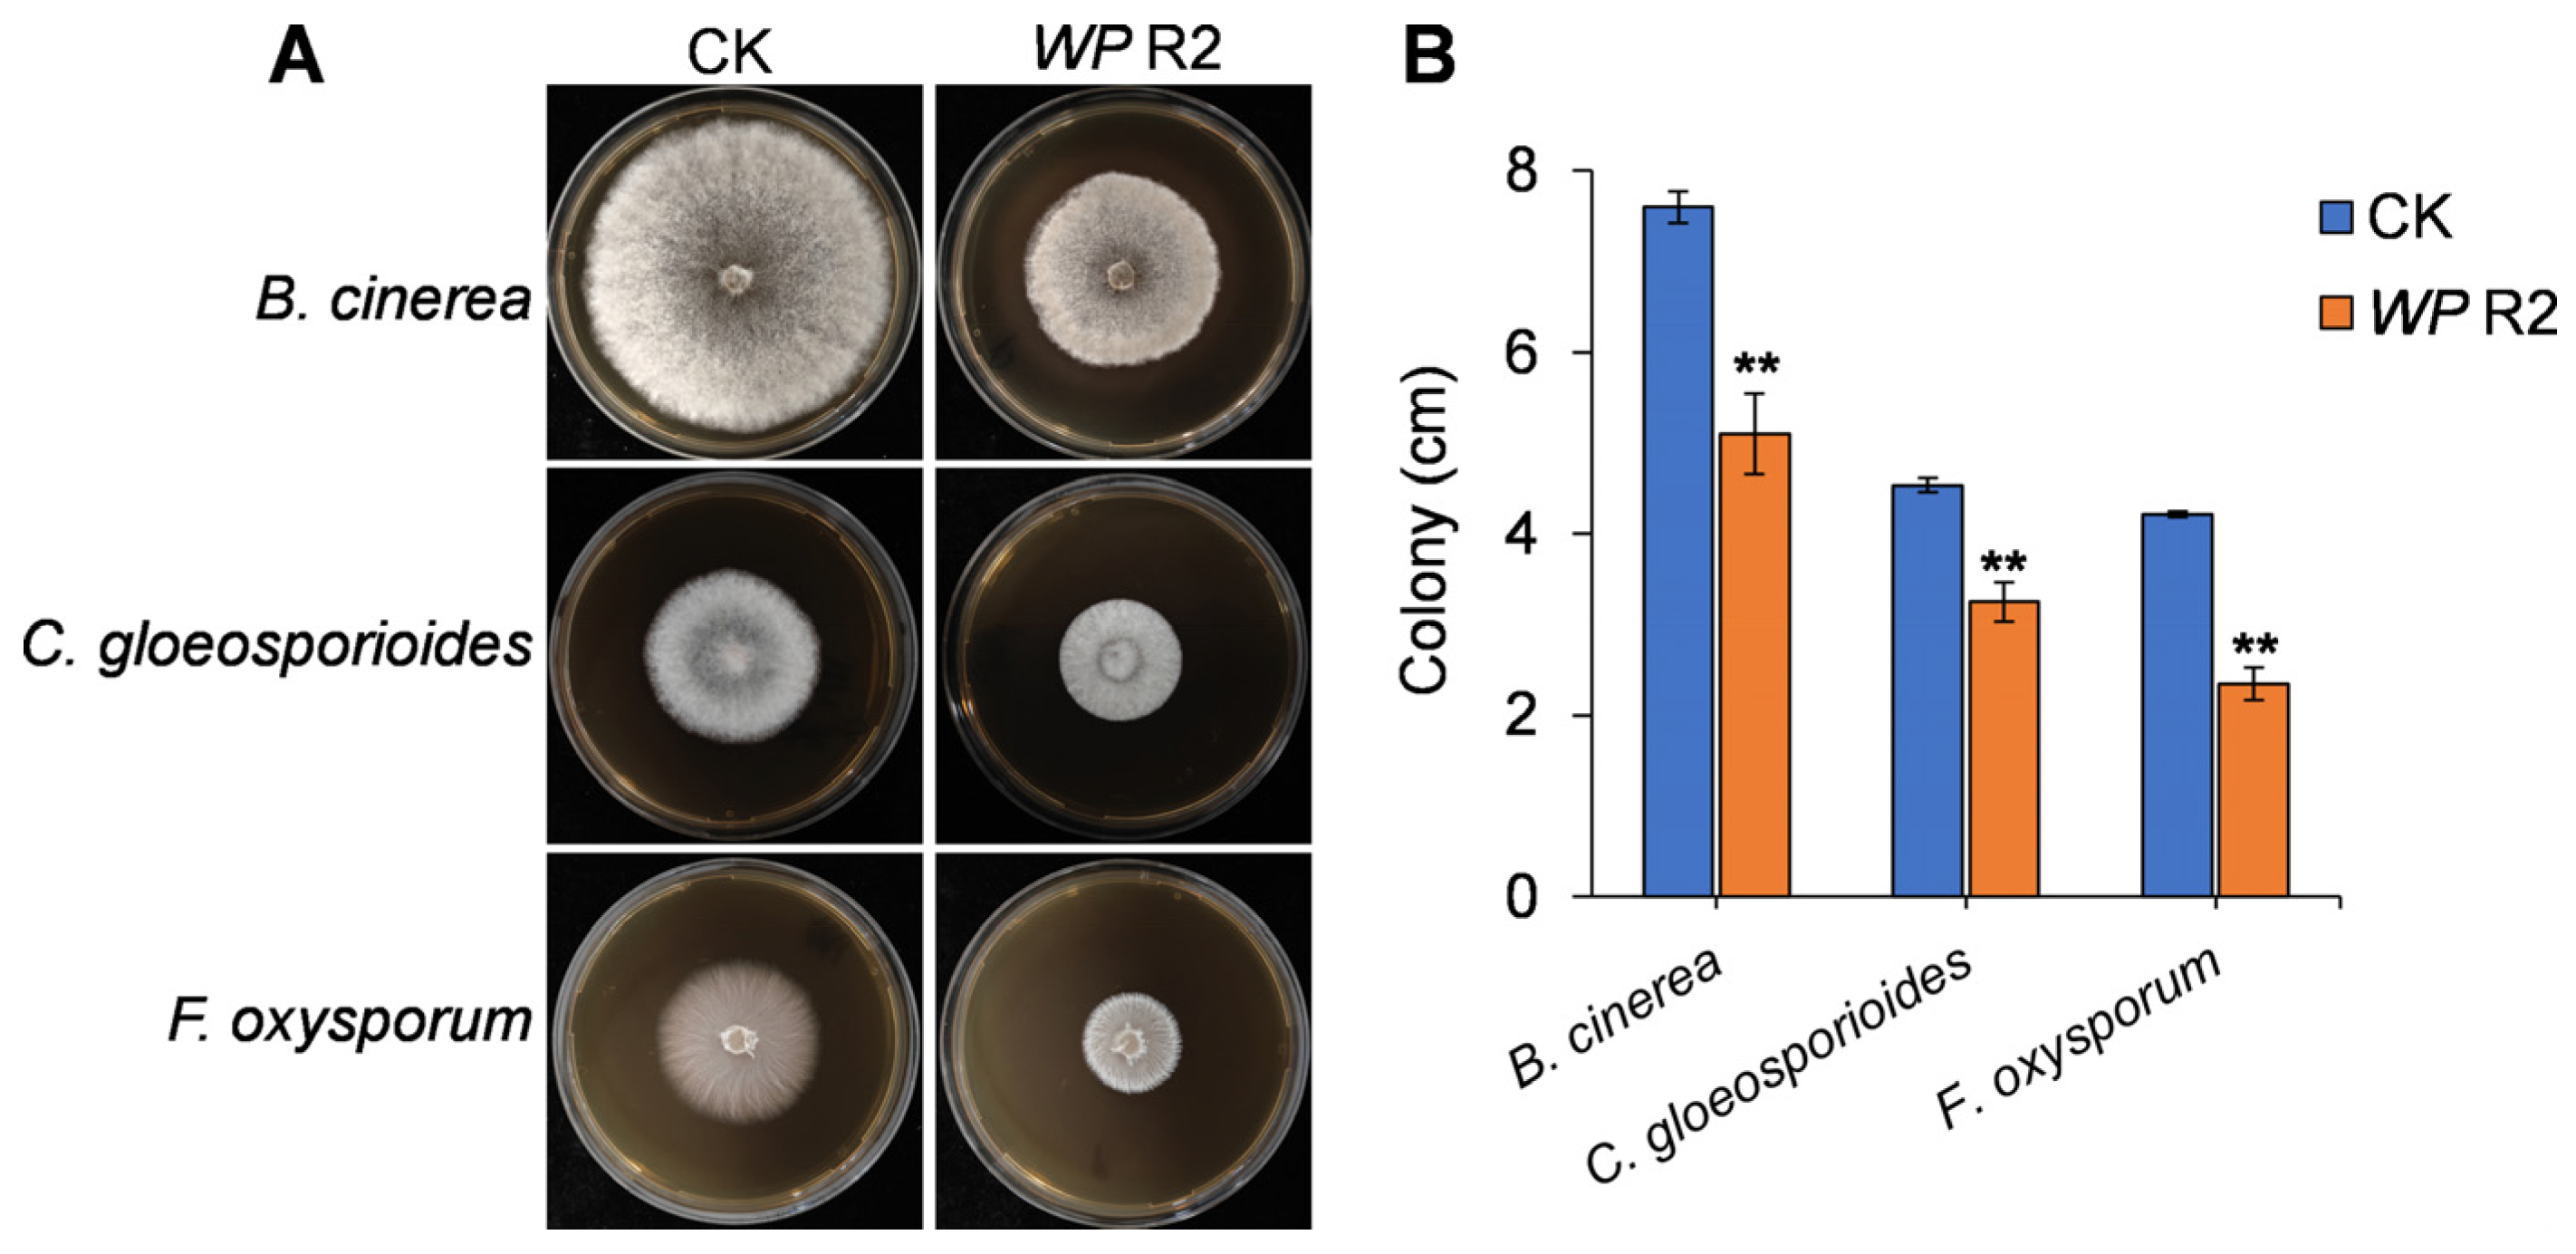
Jof 11 00538 g003

Biocontrol Potential of a Mango-Derived Weissella paramesenteroides and Its Application in Managing Strawberry Postharvest Disease
Abstract
1. Introduction
2. Materials and Methods
2.1. Isolation and Identification of Bacteria with Antifungal Activity
2.2. Screening the In Vitro Antifungal Activity of Bacteria
2.3. Evaluation of Antifungal Activity of Fermentation Broth and VOCs Produced by Strain R2
2.4. Gas Chromatography–Mass Spectrometry (GC-MS) Analysis of VOCs
2.5. Evaluation of Fruit Preservation by R2 VOCs
2.6. Statistical Analysis
3. Results
3.1. In Vitro Antagonistic Activity of R2
3.2. Morphological Observation and Molecular Identification of Strain R2
3.3. Antifungal Activity of VOCs Produced by W. paramesenteroides R2
3.4. Identification and Classification of VOCs Produced by W. paramesenteroides R2
3.5. Validation of Antifungal Activity of Key VOCs
3.6. Application of W. paramesenteroides R2 VOCs for Postharvest Disease Control in Strawberry
4. Discussion
Supplementary Materials
Author Contributions
Funding
Institutional Review Board Statement
Informed Consent Statement
Data Availability Statement
Conflicts of Interest
References
- Kumar, D.; Kalita, P. Reducing postharvest losses during storage of grain crops to strengthen food security in developing countries. Foods 2017, 6, 8. [Google Scholar] [CrossRef] [PubMed]
- Li, X.; Zeng, S.; Wisniewski, M.; Droby, S.; Yu, L.; An, F.; Leng, Y.; Wang, C.; Li, X.; He, M. Current and future trends in the biocontrol of postharvest diseases. Crit. Rev. Food Sci. 2024, 64, 5672–5684. [Google Scholar] [CrossRef] [PubMed]
- Hodges, R.J.; Buzby, J.C.; Bennett, B. Postharvest losses and waste in developed and less developed countries: Opportunities to improve resource use. J. Agric. Food Chem. 2011, 149, 37–45. [Google Scholar] [CrossRef]
- Wisniewski, M.; Droby, S.; Norelli, J.; Liu, J.; Schena, L. Alternative management technologies for postharvest disease control: The journey from simplicity to complexity. Postharvest Biol. Technol. 2016, 122, 3–10. [Google Scholar] [CrossRef]
- Pétriacq, P.; López, A.; Luna, E. Fruit decay to diseases: Can induced resistance and priming help? Plants 2018, 7, 77. [Google Scholar] [CrossRef] [PubMed]
- Kanetis, L.; Förster, H.; Adaskaveg, J.E. Comparative efficacy of the new postharvest fungicides azoxystrobin, fludioxonil, and pyrimethanil for managing citrus green mold. Plant Dis. 2007, 91, 1502–1511. [Google Scholar] [CrossRef] [PubMed]
- Schirra, M.; Aquino, S.D.; Cabras, P.; Angioni, A. Control of postharvest diseases of fruit by heat and fungicides: Efficacy, residue levels, and residue persistence. A review. J. Agric. Food Chem. 2011, 59, 8531–8542. [Google Scholar] [CrossRef] [PubMed]
- Feliziani, E.; Santini, M.; Landi, L.; Romanazzi, G. Pre-and postharvest treatment with alternatives to synthetic fungicides to control postharvest decay of sweet cherry. Postharvest Biol. Technol. 2013, 78, 133–138. [Google Scholar] [CrossRef]
- Droby, S.; Wisniewski, M.; Teixidó, N.; Spadaro, D.; Jijakli, M.H. The science, development, and commercialization of postharvest biocontrol products. Postharvest Biol. Technol. 2016, 122, 22–29. [Google Scholar] [CrossRef]
- Hernandez-Montiel, L.G.; Droby, S.; Preciado-Rangel, P.; Rivas-García, T.; González-Estrada, R.R.; Gutiérrez-Martínez, P.; Ávila-Quezada, G.D. A sustainable alternative for postharvest disease management and phytopathogens biocontrol in fruit: Antagonistic yeasts. Plants 2021, 10, 2641. [Google Scholar] [CrossRef] [PubMed]
- Boro, M.; Sannyasi, S.; Chettri, D.; Verma, A.K. Microorganisms in biological control strategies to manage microbial plant pathogens: A review. Arch. Microbiol. 2022, 204, 666. [Google Scholar] [CrossRef] [PubMed]
- Zhang, N.; Wang, Z.; Shao, J.; Xu, Z.; Liu, Y.; Xun, W.; Miao, Y.; Shen, Q.; Zhang, R. Biocontrol mechanisms of Bacillus: Improving the efficiency of green agriculture. Microb. Biotechnol. 2023, 16, 2250–2263. [Google Scholar] [CrossRef] [PubMed]
- Freimoser, F.M.; Rueda-Mejia, M.P.; Tilocca, B.; Migheli, Q. Biocontrol yeasts: Mechanisms and applications. World J. Microbiol. Biotechnol. 2019, 35, 154. [Google Scholar] [CrossRef] [PubMed]
- Sood, M.; Kapoor, D.; Kumar, V.; Sheteiwy, M.S.; Ramakrishnan, M.; Landi, M.; Araniti, F.; Sharma, A. Trichoderma: The “secrets” of a multitalented biocontrol agent. Plants 2020, 9, 762. [Google Scholar] [CrossRef] [PubMed]
- Junaid, J.M.; Dar, N.A.; Bhat, T.A.; Bhat, A.H.; Bhat, M.A. Commercial biocontrol agents and their mechanism of action in the management of plant pathogens. Int. J. Mod. Plant Anim. Sci. 2013, 1, 39–57. [Google Scholar]
- Lahlali, R.; Peng, G.; McGregor, L.; Gossen, B.D.; Hwang, S.F.; McDonald, M. Mechanisms of the biofungicide Serenade (Bacillus subtilis QST713) in suppressing clubroot. Biocontrol Sci. Technol. 2011, 21, 1351–1362. [Google Scholar] [CrossRef]
- Eshel, D. Non-chemical approaches for postharvest quality management of underground vegetables. Stewart Postharvest Rev. 2011, 7, 1–7. [Google Scholar] [CrossRef]
- Huynh, U.; Zastrow, M.L. Metallobiology of Lactobacillaceae in the gut microbiome. J. Inorg. Biochem. 2023, 238, 112023. [Google Scholar] [CrossRef] [PubMed]
- Walter, J.; O’Toole, P.W. Microbe profile: The Lactobacillaceae. Microbiology 2023, 169, 1414. [Google Scholar] [CrossRef] [PubMed]
- Parente, E.; Zotta, T.; Giavalisco, M.; Ricciardi, A. Metataxonomic insights in the distribution of Lactobacillaceae in foods and food environments. Int. J. Food Microbiol. 2023, 391, 110124. [Google Scholar] [CrossRef] [PubMed]
- Peng, S.; Xu, J.; Xu, J.; Wang, J.; Zhang, Y.; Liao, X.; Zhao, L. Microbial community and volatile metabolites related to the fermentation degree of salted fermented chili peppers. LWT 2023, 181, 114752. [Google Scholar] [CrossRef]
- Razo-Belman, R.; Ozuna, C. Volatile organic compounds: A review of their current applications as pest biocontrol and disease management. Horticulturae 2023, 9, 441. [Google Scholar] [CrossRef]
- Tamura, K.; Stecher, G.; Kumar, S. MEGA11: Molecular evolutionary genetics analysis version 11. Mol. Biol. Evol. 2021, 38, 3022–3027. [Google Scholar] [CrossRef] [PubMed]
- Lu, H.; Guo, S.; Wang, Q.; An, B. Development of a kaolin-based Bacillus velezensis BF01 composite for application in biocontrol of postharvest strawberry diseases. J. Sci. Food Agric. 2025, 105, 5507–5515. [Google Scholar] [CrossRef] [PubMed]
- Hossain, M.I.; Sadekuzzaman, M.; Ha, S. Probiotics as potential alternative biocontrol agents in the agriculture and food industries: A review. Food Res. Int. 2017, 100, 63–73. [Google Scholar] [CrossRef] [PubMed]
- Sellitto, V.M.; Zara, S.; Fracchetti, F.; Capozzi, V.; Nardi, T. Microbial biocontrol as an alternative to synthetic fungicides: Boundaries between pre-and postharvest applications on vegetables and fruits. Fermentation 2021, 7, 60. [Google Scholar] [CrossRef]
- Pabari, K.; Pithva, S.; Kothari, C.; Purama, R.K.; Kondepudi, K.K.; Vyas, B.R.M.; Kothari, R.; Ambalam, P. Evaluation of probiotic properties and prebiotic utilization potential of Weissella paramesenteroides isolated from fruits. Probiot. Antimicrob. 2020, 12, 1126–1138. [Google Scholar] [CrossRef] [PubMed]
- Prado, G.; Torrinha, K.C.; Cruz, R.E.; Gonçalves, A.; Silva, C.; Oliveira, F.; Nunes, A.C.; Gomes, M.A.; Caliari, M.V. Weissella paramesenteroides WpK4 ameliorate the experimental amoebic colitis by increasing the expression of MUC-2 and the intestinal epithelial regeneration. J. Appl. Microbiol. 2020, 129, 1706–1719. [Google Scholar] [CrossRef] [PubMed]
- Tozlu, C.; Şahin, E.; Serencam, H.; Dertli, E. Production of enantiomerically enriched chiral carbinols using Weissella paramesenteroides as a novel whole cell biocatalyst. Biocatal. Biotransform. 2019, 37, 388–398. [Google Scholar] [CrossRef]
- Wan, X.; Takala, T.M.; Huynh, V.A.; Ahonen, S.L.; Paulin, L.; Björkroth, J.; Sironen, T.; Kant, R.; Saris, P. Comparative genomics of 40 Weissella paramesenteroides strains. Front. Microbiol. 2023, 14, 1128028. [Google Scholar] [CrossRef] [PubMed]
- Apostolakos, I.; Paramithiotis, S.; Mataragas, M. Functional and safety characterization of Weissella paramesenteroides strains isolated from dairy products through whole-genome sequencing and comparative genomics. Dairy 2022, 3, 799–813. [Google Scholar] [CrossRef]
- Yun, J.; Kim, T.W.; Cho, C.; Lee, J. Antifungal mechanisms investigation of lactic acid bacteria against Aspergillus flavus: Through combining microbial metabolomics and co-culture system. J. Appl. Microbiol. 2024, 135, lxae112. [Google Scholar] [CrossRef] [PubMed]
- Lammers, A.; Lalk, M.; Garbeva, P. Air ambulance: Antimicrobial power of bacterial volatiles. Antibiotics 2022, 11, 109. [Google Scholar] [CrossRef] [PubMed]
- Contarino, R.; Brighina, S.; Fallico, B.; Cirvilleri, G.; Parafati, L.; Restuccia, C. Volatile organic compounds (VOCs) produced by biocontrol yeasts. Food Microbiol. 2019, 82, 70–74. [Google Scholar] [CrossRef] [PubMed]
- Choub, V.; Won, S.; Ajuna, H.B.; Moon, J.; Choi, S.; Lim, H.; Ahn, Y.S. Antifungal activity of volatile organic compounds from Bacillus velezensis CE 100 against Colletotrichum gloeosporioides. Horticulturae 2022, 8, 557. [Google Scholar] [CrossRef]
- Zhao, P.; Li, P.; Wu, S.; Zhou, M.; Zhi, R.; Gao, H. Volatile organic compounds (VOCs) from Bacillus subtilis CF-3 reduce anthracnose and elicit active defense responses in harvested litchi fruits. AMB Express 2019, 9, 119. [Google Scholar] [CrossRef] [PubMed]
- Wu, Y.; Zhou, J.; Li, C.; Ma, Y. Antifungal and plant growth promotion activity of volatile organic compounds produced by Bacillus amyloliquefaciens. Microbiologyopen 2019, 8, e00813. [Google Scholar] [CrossRef] [PubMed]
- Kim, B.; Park, A.R.; Song, C.W.; Song, H.; Kim, J. Biological control efficacy and action mechanism of Klebsiella pneumoniae JCK-2201 producing meso-2, 3-butanediol against tomato bacterial wilt. Front. Microbiol. 2022, 13, 914589. [Google Scholar] [CrossRef] [PubMed]
- Sdiri, Y.; Lopes, T.; Rodrigues, N.; Silva, K.; Rodrigues, I.; Pereira, J.A.; Baptista, P. Biocontrol ability and production of volatile organic compounds as a potential mechanism of action of olive endophytes against Colletotrichum acutatum. Microorganisms 2022, 10, 571. [Google Scholar] [CrossRef] [PubMed]
- Hernández-León, R.; Rojas-Solís, D.; Contreras-Pérez, M.; Del Carmen Orozco-Mosqueda, M.; Macías-Rodríguez, L.I.; Reyes-de La Cruz, H.; Valencia-Cantero, E.; Santoyo, G. Characterization of the antifungal and plant growth-promoting effects of diffusible and volatile organic compounds produced by Pseudomonas fluorescens strains. Biol. Control 2015, 81, 83–92. [Google Scholar] [CrossRef]
- Oro, L.; Feliziani, E.; Ciani, M.; Romanazzi, G.; Comitini, F. Volatile organic compounds from Wickerhamomyces anomalus, Metschnikowia pulcherrima and Saccharomyces cerevisiae inhibit growth of decay causing fungi and control postharvest diseases of strawberries. Int. J. Food Microbiol. 2018, 265, 18–22. [Google Scholar] [CrossRef] [PubMed]
- Bonde, C.G.; Gaikwad, N.J. Synthesis and preliminary evaluation of some pyrazine containing thiazolines and thiazolidinones as antimicrobial agents. Bioorgan. Med. Chem. 2004, 12, 2151–2161. [Google Scholar] [CrossRef] [PubMed]
- Grahovac, J.; Pajčin, I.; Vlajkov, V. Bacillus VOCs in the context of biological control. Antibiotics 2023, 12, 581. [Google Scholar] [CrossRef] [PubMed]
- Vlassi, A.; Nesler, A.; Perazzolli, M.; Lazazzara, V.; Büschl, C.; Parich, A.; Puopolo, G.; Schuhmacher, R. Volatile organic compounds from Lysobacter capsici AZ78 as potential candidates for biological control of soilborne plant pathogens. Front. Microbiol. 2020, 11, 1748. [Google Scholar] [CrossRef] [PubMed]
- Wu, W.; Zeng, Y.; Yan, X.; Wang, Z.; Guo, L.; Zhu, Y.; Wang, Y.; He, X. Volatile organic compounds of Bacillus velezensis GJ-7 against Meloidogyne hapla through multiple prevention and control modes. Molecules 2023, 28, 3182. [Google Scholar] [CrossRef] [PubMed]
- Kushveer, J.S.; Sharma, R.; Samantaray, M.; Amutha, R.; Sarma, V.V. Purification and evaluation of 2, 4-di-tert butylphenol (DTBP) as a biocontrol agent against phytopathogenic fungi. Fungal Biol. 2023, 127, 1067–1074. [Google Scholar] [CrossRef] [PubMed]
- Fan, K.; Yu, Y.; Hu, Z.; Qian, S.A.; Zhao, Z.; Meng, J.; Zheng, S.; Huang, Q.; Zhang, Z.; Nie, D. Antifungal activity and action mechanisms of 2, 4-Di-Tert-Butylphenol against Ustilaginoidea virens. J. Agric. Food Chem. 2023, 71, 17723–17732. [Google Scholar] [CrossRef] [PubMed]
- Chai, W.; Liu, X.; Hu, Y.; Feng, H.; Jia, Y.; Guo, Y.; Zhou, H.; Chen, Q. Antityrosinase and antimicrobial activities of furfuryl alcohol, furfural and furoic acid. Int. J. Biol. Macromol. 2013, 57, 151–155. [Google Scholar] [CrossRef] [PubMed]
- Calvo, H.; Mendiara, I.; Arias, E.; Gracia, A.P.; Blanco, D.; Venturini, M.E. Antifungal activity of the volatile organic compounds produced by Bacillus velezensis strains against postharvest fungal pathogens. Postharvest Biol. Technol. 2020, 166, 111208. [Google Scholar] [CrossRef]
- Huang, X.; Ren, J.; Li, P.; Feng, S.; Dong, P.; Ren, M. Potential of microbial endophytes to enhance the resistance to postharvest diseases of fruit and vegetables. J. Sci. Food Agric. 2021, 101, 1744–1757. [Google Scholar] [CrossRef] [PubMed]

| Number | Name | Chemical Subclass | Abundance (%) |
|---|---|---|---|
| 1 | 2,5-dimethyl-Pyrazine | Pyrazines | 14.86 |
| 2 | 2,4-Di-tert-butylphenol | Phenylpropanes | 8.69 |
| 3 | 2-Furanmethanol | Heteroaromatic compounds | 5.77 |
| 4 | methyl-Pyrazine | Pyrazines | 5.47 |
| 5 | 2-ethyl-1-Hexanol | Fatty alcohols | 3.36 |
| 6 | 2,6-dimethyl-Pyrazine | Pyrazines | 2.90 |
| 7 | 3-methyl-1-Butanol | Alcohols and polyols | 2.81 |
| 8 | Pyrazine | Pyrazines | 2.60 |
| 9 | trimethyl-Pyrazine, | Pyrazines | 1.30 |
| 10 | 3-methyl-Butanoic acid | Fatty acids and conjugates | 1.00 |
Disclaimer/Publisher’s Note: The statements, opinions and data contained in all publications are solely those of the individual author(s) and contributor(s) and not of MDPI and/or the editor(s). MDPI and/or the editor(s) disclaim responsibility for any injury to people or property resulting from any ideas, methods, instructions or products referred to in the content. |
© 2025 by the authors. Licensee MDPI, Basel, Switzerland. This article is an open access article distributed under the terms and conditions of the Creative Commons Attribution (CC BY) license (https://creativecommons.org/licenses/by/4.0/).
Share and Cite
Zhang, X.; An, B. Biocontrol Potential of a Mango-Derived Weissella paramesenteroides and Its Application in Managing Strawberry Postharvest Disease. J. Fungi 2025, 11, 538. https://doi.org/10.3390/jof11070538
Zhang X, An B. Biocontrol Potential of a Mango-Derived Weissella paramesenteroides and Its Application in Managing Strawberry Postharvest Disease. Journal of Fungi. 2025; 11(7):538. https://doi.org/10.3390/jof11070538
Chicago/Turabian StyleZhang, Xiyu, and Bang An. 2025. "Biocontrol Potential of a Mango-Derived Weissella paramesenteroides and Its Application in Managing Strawberry Postharvest Disease" Journal of Fungi 11, no. 7: 538. https://doi.org/10.3390/jof11070538
APA StyleZhang, X., & An, B. (2025). Biocontrol Potential of a Mango-Derived Weissella paramesenteroides and Its Application in Managing Strawberry Postharvest Disease. Journal of Fungi, 11(7), 538. https://doi.org/10.3390/jof11070538

